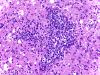
Com408-2-3.gif (189666 bytes)
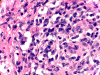
Com408-2-1.gif (157011 bytes)

| A 55 year-old Woman with
Granulomatous Dermitits and Cerebral Masses. August, 2004, Case 408-2. Home Page |
Arie Perry, M.D. 1, Kar-Ming Fung, M.D., Ph.D. 2 Last update: August 30, 2004.
1 Department of Pathology, Washington University, St. Louis, Missouri, and 2 Department of Pathology, University of Oklahoma Health Sciences Center, Oklahoma City, Oklahoma.
A 55 year-old woman with granulomatous dermititis and cerebral masses
Clinical information: The patient was a 55-yo woman with a history of myasthenia gravis and was treated with steroids. She recently had a skin biopsy which showed a granulomatous dermatitis with acid fast organisms, cultured out as M. kansasii. She presented later with mild confusion and 2 separate enhancing cerebral masses. MRI revealed multiple lesions in the brain. A left thalamic biopsy was performed to rule out infection.
|
 |
|

|
||
| A. | B. | C. | D. |
Pathology of the case:
Histopathology: There is a necrotizing process with granulomatous reaction and perivascular lymphocytic infiltration. In some areas, there is concentric, perivascular lymphocytic infiltration surrounded by a granulomatous reaction (Panel A). On higher magnification, the lymphocytic infiltration appears to contain both small lymphocytes and scattered atypical cells with increased mitotic activity (Panel B and C). No definitive viral inclusion bodies are identified.
Special stains and Cultures: GMS stain, AFB stain, and immunohistochemistry for toxoplasma were negative. The large atypical cells were positive for CD20 (Panel D), and to a lesser extent CD30 and Epstein-Barr virus (EBV). Immunohistochemistry for CD68 highlighted numerous histiocytes, including those within vague granulomas. Numerous reactive T-cells were demonstrated by immunohistochemistry for CD45RO, CD2, CD3, CD5, CD7, and CD8, but not CD4.
|
DIAGNOSIS: Non-Hodgkin's lymphoma, large B-cell type, with extensive granulomatous inflammation. |
Comment on this case: This case was diagnosed as non-Hodgkin's lymphoma, large-B cell type, with extensive granulomatous inflammation. The histologic pattern in this case was complex and unusual, lending itself to a very wide differential, including lymphoma, infection, and collagen vascular disorders. Granulomatous reaction occuring in the central nervous system (CNS) has been well documented in acid fast bacilli infection, plasma cell granulomas, germinoma with extensive granulomatous changes in the pineal gland, and other conditions.
Lymphoma with extensive granulomatous changes, however, is rare in the CNS. Lymphoma with extensive granulomatous inflammation has been well documented in T-cell lymphoma, particularly those occurring in the skin. Granulomatous inflammation in B-cell lymphoma is uncommon but it has been documented. Interestingly, some of these cases are associated with EBV. The necrosis and EBV immunoreactivity being illustrated here are more typical of CNS lymphomas in immunosuppressed patients, such as this one.
Discussion:
General Information Imaging Pathology Pathogenesis Granulomatous changes in lymphoma Differential diagnosis
General Information
Primary CNS lymphoma (PCL) was a rare tumor before 1980 and represented about 1% of all brain tumors 1. A dramatic increase in incidence occurred after 1980 and is partly resulted from the \acquired immune deficiency syndrome (AIDS) epidemics 2, 3. The estimated incidence of PCL in the general population is 4.7 per 1000 person-year. The incidence of PCL in AIDS patients is about 3,600 times higher than in the general population 3.
Most PCL are B-cell, non-Hodgkin’s lymphoma. Primary T-cell PCL are rare and primary Hodgkin’s lymphoma is almost unknown in the brain. In immune competent patients, PCL occurs most commonly in the 6th and 7th decades with a slight male predominance. However, patients of any age can be affected. In immune compromised patients, there is a small peak of incidence in patients under 10 years of age with many of these cases associated with congenital immune deficiency. A much larger peak occur in the 4th decade of life with most of them occurring in recipients of organ transplantation and AIDS patients. Transplantation associated PCL mostly occur within 1-2 years after transplantation. Human immune deficiency virus (HIV) associated PCL occur predominantly in male and these tumors tend to occur at the final stages of full-blown AIDS syndrome. [See related case 1] [See related case 2] [See related case 3]
Similar to other tumors of the CNS, the clinical manifestations depend on the location. The symptoms can range from frontal lobe signs and symptoms, seizure, visual disturbance, headache, motor dysfunction, signs and symptoms of increased intracranial pressure.
Multiple lesions are common and often occur in a symmetrical pattern of distribution. The cerebral, subependymal white matter is a common site. The corpus callosum, basal ganglia, and thallmus are often affected. On MRI, PCL may appear well defined. They are hypointense to isointense on T1-weighted images and isointense to hyperintense on T2-weighted images. Heterogeneous enhancement is common. Ring enhancing lesions may occur and would make it difficult to distinguish PCL from infections particularly toxoplasmosis. PCL is also one of the few entities that my cross the corpus and generate “butterfly tumors” similar to that generated by glioblastomas. A combination with other pathologic process such as progressive multifocal leukoencephalopy, paticularly in AIDS patients, further complicates the picture.
Macroscopically, PCL are usually deep seated tumors. They occur as either solitary or multiple lesions. Although the margins appear well defined on MRI, their gross delineation is usually poor. Hemorrhage and necrosis may be seen. Some of them may occur as dural based tumors.
Cytologic preparations (smears or squashed preparations) in combination with a Romanowski type of stain (e.g., DIffQuick) are extremely helpful for intraoperative diagnosis. PCL also exhibit a characteristic concentric perivascular arrangement. This feature is far more easy to be detected with cryostat sections than cytologic preparations during intraoperative operations. Once a diagnosis of lymphoproliferative disorder including lymphoma is suspected during intraoperative consultation, tissue should be sent for flow cytometry for characterization.
Most PCL are diffuse large B-cell lymphomas. On paraffin sections, the neoplastic lymphocytes have hyperchromatic, pleomorphic nuclei. Individual cell necrosis is common. In less affected areas, concentric infiltration of blood vessels with dissection of reticulin fibers are classic findings. A variable degree of infiltration of the atypical lymphocytes radiate out from these perivascular infiltrations. In areas with high tumor load, the infiltrating lymphoma cells coalescence into solid tumor sheets that appear like a small blue cell tumor. Individual cell necrosis, small en masse necrosis, and brisk mitotic activity are common. The background is often gliotic. A variable amount of small, reactive lymphocytes often admix with the large, atypical cells. In patients with AIDS, large Butrkitt-type-B-cell lymphoma may occur. Steroid treatment shortly before biopsy will reduce the amount of atypical cells and make the diagnosis a difficult one.
Many PCL do not express CD45 (LCA), the pan-leukocyte marker, and this marker is not an effective tool to rule in or rule out lymphoma. Most B-cell lymphomas express B-cell markers such as CD20. Clonal restriction, usually IgM k, can be detected by either immuhistochemistry or flow cytometry. A variable amount of reactive T-cells can be demonstrated by immunohistochemistry. When T-cells are in large amount, they can cause diagnosis difficulties. In addition, T-cell rich B-cell lymphomas should also be considered in this situation. Diffuse large B-cell lymphoma of the brain carries a grave prognosis.
MALT-lymphoma is an indolent B-cell lymphoma can also occur but they are uncommon. They tend to arise in adult immune competent females and have a favorable response to treatment. T-cell PCL are rare.
Epstein-Barr virus (EBV) is related to lymophoproliferative diseases including infectious mononucleosis and post-transplantation lymphoproliferative disorder. EBV is also related to a variety of primary hematopoietic and non-hematopoietic neoplasia including Burkitt's lymphoma, lymphomas associated with immunosuppression, other non-Hodgkin's lymphomas, Hodgkin's disease, nasopharyngeal carcinoma, gastric adenocarcinoma, lymphoepithelioma-like carcinomas, and immunodeficiency-related leiomyosarcoma 4. These tumors occur in both immune competent and compromised patients. The latent membrane protein 1 (LMP1) in EBV appears to play an important role in tumorigenesis of EBV associated lymphomas 5. In recipients of organ transplantation, EBV are associated with post-transplantation lymphoproliferative disorders, lymphomas and leiomyosarcomas 6, 7, 8. The association between EBV in PCL arising from immunocompromised patient is almost constant as illustrated in this case.
Granulomatous changes in lymphoma
Extensive granulomatous change in lymphoma is uncommon. Most of them are associated with T-cell lymphoma of the skin 9, 10 and also lymphoma of the sinunasal mucosa 11, 12. Cutaneous extravascular necrotizing granulomas have also been described as a paraneoplastic disease in patients with non-Hodgkin’s B-cell lymphoma 13.
Granulomatous change in B-cell lymphomas is far less common but they have been well documented. These granulomatous changes have been associated with high-grade and low-grade lymphomas 14, 15, 16, 17, 18. Association with EBV and HTLV-1 have also been described 17, 18.
Differential diagnosis
The differential diagnoses in this case are broad. The emphasis is on both granulomatous inflammation and neoplastic conditions. First and foremost, it is important to rule out infection by special stains and immunohistochemistry. Secondary involvement by lymphoma or leukemia arising outside the CNS must be ruled out.
Extensive granulomatous changes can occur in germinoma which makes the diagnosis difficult, particularly in stereotatic biopsies 19. Keen identification of large atypical cells is important. Geminoma cells are also immunoreactive for placenta alkaline phosphatase (PLAP) and CD117 (c-kit). Germinoma occur most commonly in the pineal gland and sellar/suprasellar regions.
Plasma cell granuloma represents another diagnostic challenge 20 . This is an inflammatory non-neoplastic lesion characterized by a large amount of plasma cells and a variable amount of granulomatous reaction. Plasma cell granulomas often have whorled fibrobloblastic foci. The high-degree of atypia that would occur in B-cell lymphoma would not be observed here. They occur most frequently in the lungs, and also in other organs such as thyroid gland, kidney, stomach and urinary bladder. It is more then likely to see lesions in other part of the body than isolated lesions in the CNS. When they occur in the brain, they tend to be solitary rather then multiple.
The list of differential diagnosis also include other hemopoietic neoplastic and non-neoplastic conditions such as MALT-type lymphoma, Rosai-Doffman’s disease and Langerhans’ histiocytosis. It is uncommon for these lesions to develop extensive granulomatous changes. In their native form, they can be easily distinguished from a B-cell lymphoma by both histologic and immunohistochemical features.
Reference:
Jellinger K, Radaskiewicz TH, Slowik F. Primary malignant lymphomas of the central nervous system in man. Acta Neuropathol Suppl (Berl). 1975;Suppl 6:95-102.
Cote TR, Manns A, Hardy CR, Yellin FJ, Hartge P. Epidemiology of brain lymphoma among people with or without acquired immunodeficiency syndrome. AIDS/Cancer Study Group. J Natl Cancer Inst. 1996 88:675-9.
Camilleri-Broet S, Davi F, Feuillard J, Seilhean D, Michiels JF, Brousset P, Epardeau B, Navratil E, Mokhtari K, Bourgeois C, Marelle L, Raphael M, Hauw JJ.AIDS-related primary brain lymphomas: histopathologic and immunohistochemical study of 51 cases. The French Study Group for HIV-Associated Tumors. Hum Pathol. 1997 28:367-74.
Hsu JL, Glaser SL. Epstein-barr virus-associated malignancies: epidemiologic patterns and etiologic implications. Crit Rev Oncol Hematol. 2000 34:27-53.
Liebowitz D. Epstein-Barr virus and a cellular signaling pathway in lymphomas from immunosuppressed patients. N Engl J Med. 1998 338:1413-21.
Loren AW, Porter DL, Stadtmauer EA, Tsai DE. Post-transplant lymphoproliferative disorder: a review. Bone Marrow Transplant. 2003 3:145-55.
Monforte-Munoz H, Kapoor N, Saavedra JA. Epstein-Barr virus-associated leiomyomatosis and posttransplant lymphoproliferative disorder in a child with severe combined immunodeficiency: case report and review of the literature. Pediatr Dev Pathol. 2003 6:449-57.
Brichard B, Smets F, Sokal E, Clapuyt P, Vermylen C, Cornu G, Rahier J, Otte JB. Unusual evolution of an Epstein-Barr virus-associated leiomyosarcoma occurring after liver transplantation. Pediatr Transplant. 2001 5:365-9.
Higaki Y, Mizushima J, Kawashima M, Motoji T, Mizoguchi H. Cutaneous granulomas associated with adult T-cell leukemia/lymphoma. Dermatology. 2003 206:157-60.
Setoyama M, Katahira Y, Kanzaki T, Kerdel FA, Byrnes JJ. Adult T-cell leukemia/lymphoma associated with noninfectious epithelioid granuloma in the skin: a clinicopathologic study. Am J Dermatopathol. 1997 19:591-5.
Lee PY, Freeman NJ, Khorsand J, Weinstock MA. Angiocentric T-cell lymphoma presenting as lethal midline granuloma. Int J Dermatol. 1997 36:419-27.
Vidal RW, Devaney K, Ferlito A, Rinaldo A, Carbone A. Sinonasal malignant lymphomas: a distinct clinicopathological category. Ann Otol Rhinol Laryngol. 1999 108:411-9.
Calonje JE, Greaves MW. Cutaneous extravascular necrotizing granuloma (Churg-Strauss) as a paraneoplastic manifestation of non-Hodgkin's B-cell lymphoma. J R Soc Med. 1993 86:549-50.
Esson MD, Bird E, Irvine GH. Lymphoma presenting as parotid xanthogranulomatous sialadenitis. Br J Oral Maxillofac Surg. 1998 36:465-7.
Blanco M, Ratzan J, Cabello-Inchausti B, Fernandes L. Necrotizing granulomas in B-cell chronic lymphocytic leukemia/small lymphocytic lymphoma. Ann Diagn Pathol. 2002 6:216-21.
Dunphy CH, Panella MJ, Grosso LE. Low-grade B-cell lymphoma and concomitant extensive sarcoidlike granulomas: a case report and review of the literature. Arch Pathol Lab Med. 2000 124:152-6.
Haralambieva E, Rosati S, van Noesel C, Boers E, van Marwijk Kooy M, Schuuring E, Kluin P. Florid granulomatous reaction in Epstein-Barr virus-positive nonendemic Burkitt lymphomas: report of four cases. Am J Surg Pathol. 2004 28:379-83.
Lewis JM, Vasef MA, Seabury Stone M. HTLV-I-associated granulomatous T-cell lymphoma in a child. J Am Acad Dermatol. 2001 44:525-9.
Kraichoke S, Cosgrove M, Chandrasoma PT. Granulomatous inflammation in pineal germinoma. A cause of diagnostic failure at stereotaxic brain biopsy. Am J Surg Pathol. 1988 12:655-60.
Brandsma D, Jansen GH, Spliet W, Van Nielen K, Taphoorn MJ. The diagnostic difficulties of meningeal and intracerebral plasma cell granulomas--presentation of three cases. J Neurol. 2003 250:1302-6.